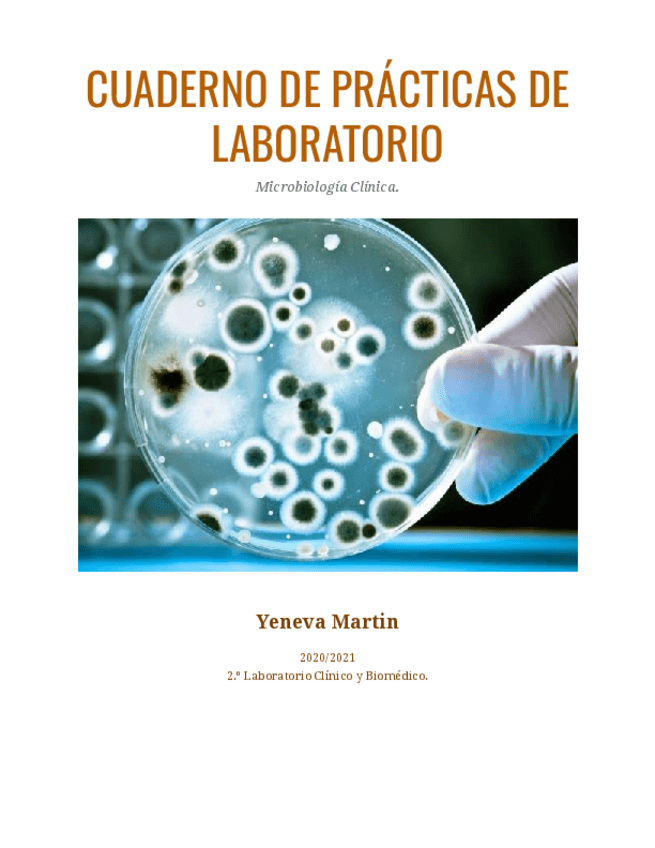

@Yenevamrtn
Bio: Estudiante de Biologia en la UNEX
101 Publicaciones
2.49k Interacciones
29 Seguidores
0 Siguiendo
Lista de publicaciones de Yenevamrtn
He publicado nuevos apuntes de Técnicas de inmunodiagnóstico: CUADERNO-DE-PRACTICAS-DE-LABORATORIO-INMUNO-2o.pdf
He publicado nuevos apuntes de Técnicas de análisis hematológico: CUADERNO-DE-PRACTICAS-DE-LABORATORIO-HEMA-2o.pdf
He publicado nuevos apuntes de Análisis bioquímico: PRACTICAS-DE-LABORATORIO-BIOQ-2o.pdf
He publicado nuevos apuntes de Microbiología clínica: PRACTICAS-DE-LABORATORIO-MICRO-2o.pdf
He publicado nuevos apuntes de Empresa e Iniciativa Emprendedora: Proyecto-de-empresas.pdf
He publicado nuevos apuntes de Proyecto de laboratorio clínico y biomédico: Lupus-Eritematoso-Sistemico.pdf
He publicado nuevos apuntes de Análisis bioquímico: Actividades-T8-Bioquimica.pdf
He publicado nuevos apuntes de Análisis bioquímico: Actividades-T7-Bioquimica.pdf
He publicado nuevos apuntes de Análisis bioquímico: Actividades-T6-Bioquimica.pdf
He publicado nuevos apuntes de Análisis bioquímico: Actividades-T5-Bioquimica.pdf
He publicado nuevos ejercicios de Análisis bioquímico: VIAJE-AL-INTERIOR-DEL-CUERPO-HUMANO-Bioquimica-1.pdf
He publicado nuevos ejercicios de Análisis bioquímico: Actividades-T4-Bioquimica-2.pdf
He publicado nuevos ejercicios de Análisis bioquímico: Actividades-T3-Bioquimica-1.pdf
He publicado nuevos ejercicios de Análisis bioquímico: Actividades-T2-Bioquimica.pdf
He publicado nuevos ejercicios de Análisis bioquímico: Actividades-T1-Bioquimica.pdf
He publicado nuevos otros de Gestión de muestras biológicas: Actividades-Gestion-T11.pdf
He publicado nuevos otros de Gestión de muestras biológicas: Actividades-Gestion-T10.pdf
He publicado nuevos otros de Gestión de muestras biológicas: Esquema-T10-Gestion.pdf
He publicado nuevos otros de Gestión de muestras biológicas: Actividades-Gestion-T9.pdf
He publicado nuevos otros de Gestión de muestras biológicas: Nuevo-esquema-T9-Gestion.pdf